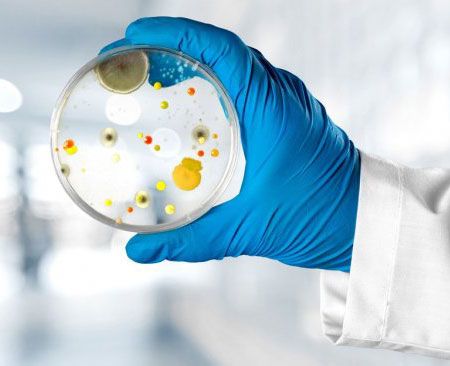

Laboratório Verde: Como Utilizar Tecnologias Avançadas para Maximizar a Produtividade Agrícola
No Laboratório Verde, a integração de tecnologias avançadas permite que produtores agrícolas tomem decisões mais precisas e eficientes.…
Ler maisExperiência,tecnologia e qualidade unidas para sua confiança.
Na MinasLab, oferecemos serviços de alta qualidade que impulsionam a excelência em análises laboratoriais. Com uma equipe dedicada de profissionais altamente qualificados, utilizamos tecnologia de ponta para fornecer resultados precisos e confiáveis. Nossos serviços abrangem uma ampla gama de análises laboratoriais de análises ambientais e alimentos. Priorizamos a satisfação do cliente, garantindo prazos rápidos e atendimento personalizado. A MinasLab é a sua parceira confiável em soluções laboratoriais de última geração
Criamos uma área especial para que você possa enviar as suas dúvidas e sugestões. Será um prazer ajudá-lo!
A CEO Lidyane Alves Oliveira, uma profissional com duas décadas de experiência na linha de frente da gestão de laboratórios e indústrias alimentícias. Com uma base sólida em Química Técnica e Biologia, e especializações que vão desde o Controle de Qualidade em Alimentos até um MBA em Gestão da Qualidade e Processos, Lidyane não apenas liderou equipes gerenciais, mas também se destacou em consultorias, treinamentos e auditorias, colaborando com uma vasta gama de empresas do setor.
Nossa equipe está pronta para atendê-lo da melhor forma. Basta clicar no botão para ser direcionado ao WhatsApp da MinasLab e agendar sua análise

No Laboratório Verde, a integração de tecnologias avançadas permite que produtores agrícolas tomem decisões mais precisas e eficientes.…
Ler mais
Embarque em uma jornada rumo à agricultura sustentável! No MinasLab, desvendamos os segredos de práticas laboratoriais que promovem…
Ler mais
Empresas que atuam em qualquer atividade com impacto potencial ao meio ambiente precisam manter um controle rigoroso sobre…
Ler mais